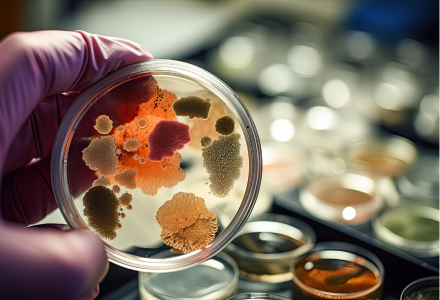

Pharma Industry
- Digestive Aids
- Anti Tumoral
- Anti Inflammatory agent
- Anti Bacterial
- Drug Formulations
FOOD & BEVERAGE
- Meat tenderiser
- Biscuit & cake making, for hydrolysing/ transforming gluten.
- As a raising/ leavening agent.
- Flavouring agent.
- Seasoning agent.
- In confectionery products.
- Thickening agent.


NUTRACEUTICALS
- Body building/ weight gaining.
- Weight reducing
- Helping digestion
- Fat reducing
- Immunity booster
COSMETICS
- Hydrating skin
- As a conditioner/ moisturizer
- In toothpaste, as a whitener
- Skin exfoliator for dead skin cell removal
- Skin rejuvenator / Anti-ageing
- Skin toner, serums.


DAIRY
- Dairy whitener
- Cheese processing and ice cream making
DIETARY
- Protein supplements


PROTEIN HYDROLYSING
- Hydrolysing soya, casein, wheat, fish, gelatine, rice, meat & pea.
PET FOOD
- Palatability enhancer
- Improving digestion
- Healthy joints
- Strengthening immune system
- Protein source in animal feed


LEATHER / TEXTILE
- For bating in leather
- Stain removal in textile
- Soaps detergents
MICROBIAL
- Media ingredients

AGRICULTURE
- Nitrogen source in bio fertilizer
